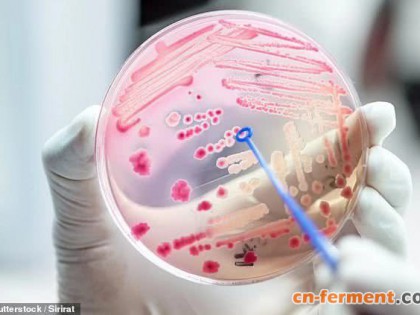

丙酮、乙醇、丁醇(acetone-ethanol-butanol,以下简称ABE)发酵是一项传统的大宗发酵工业,然而,利用粮食作物生产ABE引起人们对粮食安全与环境影响的忧虑,但秸秆ABE的最大优势在于避免了“道德风险”,一旦产业化生产,秸秆ABE可以解决“与人争粮”的问题,还可以变废为宝。我国可利用的秸秆每年在7×108 t左右,这些农业废弃物是ABE生产的丰富来源。
秸秆类生物质在发酵前需要进行预处理,预处理后会生成葡萄糖、木糖等可发酵性糖,同时会产生大量盐类物质、酸类物质、醛类物质和酚类物质等抑制物。ABE生产菌对葡萄糖和木糖都有较高的利用效率,但对酚类、醛类等抑制物比较敏感,因此以秸秆水解物为底物发酵时需要进行复杂脱毒处理。目前常用的脱毒方法有物理法、化学法和生物法,但在实际应用中单一方法难以满足发酵需求,通常是各种方法综合利用。这些脱毒方法明显增加了生产成本,限制了利用秸秆生产ABE的产业化。因此,只有针对性地开发廉价、操作性高的生产工艺,避开脱毒工艺,才能真正实现以秸秆为原料生产ABE。
成都生物所研究人员为了解决秸秆类原料预处理后需要复杂脱毒工艺才能用于ABE发酵的问题,发明一种以秸秆为原料发酵生产丙酮、乙醇、丁醇的方法,该方法包括秸秆的预处理、秸秆的酶水解、发酵培养基的配制、ABE生产微生物种子液的制备、ABE发酵、溶剂蒸馏工艺单元,通过在ABE发酵单元单添加FeSO4.7H2O促进发酵,提高溶剂产量和生产效率,从而降低了生产成本,简化了生产工艺。